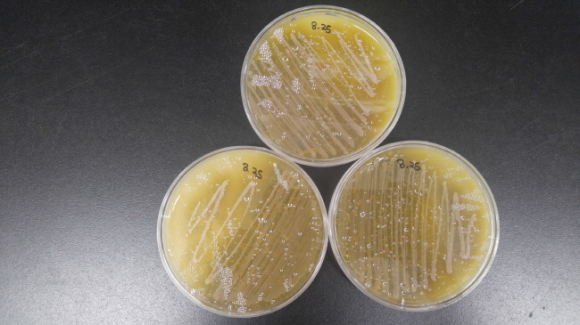

상주시, “발효식초용 초산균 종균”분양
다양한 농특산물을 활용한 농가형 고급 식초 생산 기대
황재임 기자 / gbn.tv@hanmail.net 입력 : 2016년 09월 21일 입력 : 2016년 09월 21일
| | | | ⓒ GBN 경북방송 | |
상주시농업기술센터(소장 육심교)는 9월 22일부터 10회에 걸쳐 고품질 농가형 식초 생산을 위한 초산균을 무료로 분양한다.
농업기술센터는 급변하는 농업 환경에 대비하고, 소비자의 건강에 대한 트렌드 변화에 발맞추어 새로운 소득원을 발굴하기 위해 발효식품 관련 교육과 시범사업을 실시하였다.
이와 연계하여 ‘15년~’16년 고급명품 식초교육 이수생 70명을 대상으로 초산균을 분양한다.
농업기술센터에서 분양하는 초산균은 경북농업기술원이 자체 개발한 특허 초산균(Acetobacter sp. SYL3-10)이며,
초산균은 알코올을 산화하여 초산을 만드는 세균으로,
초산균 사용 시기는 원재료의 알코올발효 후 이며, 여과 후에 초산균을 접종하면 된다.
농업기술센터 관계자는 “초산균 분양을 통해 농가의 식초제조 공정의 표준화 및 품질의 균일화, 농산물의 고부가가치 창출로 농가의 직접적인 소득증대와 연결될 수 있을 것으로 기대된다.”고 밝혔다. |
황재임 기자 / gbn.tv@hanmail.net  입력 : 2016년 09월 21일 
- Copyrights ⓒGBN 경북방송. 무단 전재 및 재배포 금지 -
|
|
포토뉴스
청명하던 하늘 먹구름 몰려와 빗줄기 우두둑우두둑..
|
극장 문이 열리자 사람들이 쏟아져나오고 피부에서 붉은빛이 번져
..
|
현관문을 열고 들어선다 텅 빈 복도에서 잠시 마음을 내려놓는다 방으로 ..
|
최동호 교수의 정조대왕 시 읽기
정조는 1752년 임신년에 출생하여 영조 35년 1759년 기묘년 2월..
|
 회원가입
회원가입